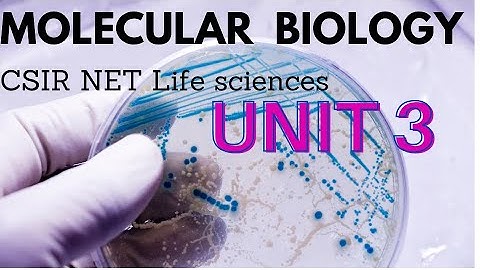
CSIR NET life science molecular biology

⬇ DOWNLOAD NOW
Kalau muncul iklan pop-up, tutup lalu klik tombol kembali
Download lagu Syllabus and Books for Molecular Biology CSIR NET JRF Life Sciences Unit 3 Unit 13 secara gratis hanya untuk keperluan promosi. Dukung artis favorit kamu dengan membeli musik original di iTunes atau platform resmi lainnya.
 L01 - Isolation and Purification of DNA, RNA & Protein - Methods in Biology - Unit 13 - CSIR NET JRF
L01 - Isolation and Purification of DNA, RNA & Protein - Methods in Biology - Unit 13 - CSIR NET JRF
 Syllabus and Books for Molecular Biology (Malayalam) CSIR NET JRF Life Sciences Unit 3 Unit 13
Syllabus and Books for Molecular Biology (Malayalam) CSIR NET JRF Life Sciences Unit 3 Unit 13
 csir net life science unit 3 most important topics | CSIR NET molecular biology #csirnetlifescience
csir net life science unit 3 most important topics | CSIR NET molecular biology #csirnetlifescience
 CSIR NET life science unit 3 | CSIR NET study plan for syllabus unit 3 | CSIR net molecular biology
CSIR NET life science unit 3 | CSIR NET study plan for syllabus unit 3 | CSIR net molecular biology
 Unit 3 - Molecular Biology - CSIR NET Previous Year Question June 2024 - Shift I - Life Science
Unit 3 - Molecular Biology - CSIR NET Previous Year Question June 2024 - Shift I - Life Science
 𝐔𝐍𝐈𝐓 𝟑 𝐌𝐨𝐥𝐞𝐜𝐮𝐥𝐚𝐫 𝐁𝐢𝐨𝐥𝐨𝐠𝐲 𝐈 𝐂𝐒𝐈𝐑-𝐍𝐄𝐓 𝐋𝐈𝐅𝐄 𝐒𝐂𝐈𝐄𝐍𝐂𝐄 𝐈 𝐌𝐄𝐆𝐀 𝐑𝐄𝐕𝐈𝐒𝐈𝐎𝐍 𝐈 𝐀𝐬𝐡𝐢𝐬𝐡 𝐊𝐫. 𝐃𝐰𝐢𝐯𝐞𝐝𝐢 𝐈
𝐔𝐍𝐈𝐓 𝟑 𝐌𝐨𝐥𝐞𝐜𝐮𝐥𝐚𝐫 𝐁𝐢𝐨𝐥𝐨𝐠𝐲 𝐈 𝐂𝐒𝐈𝐑-𝐍𝐄𝐓 𝐋𝐈𝐅𝐄 𝐒𝐂𝐈𝐄𝐍𝐂𝐄 𝐈 𝐌𝐄𝐆𝐀 𝐑𝐄𝐕𝐈𝐒𝐈𝐎𝐍 𝐈 𝐀𝐬𝐡𝐢𝐬𝐡 𝐊𝐫. 𝐃𝐰𝐢𝐯𝐞𝐝𝐢 𝐈
CSIR NET life science molecular biology
CSIR NET life science molecular biology
 CSIR NET UNIT 3 Complete Preparation & Revision Guide - CSIR NET How To & What To Series
CSIR NET UNIT 3 Complete Preparation & Revision Guide - CSIR NET How To & What To Series